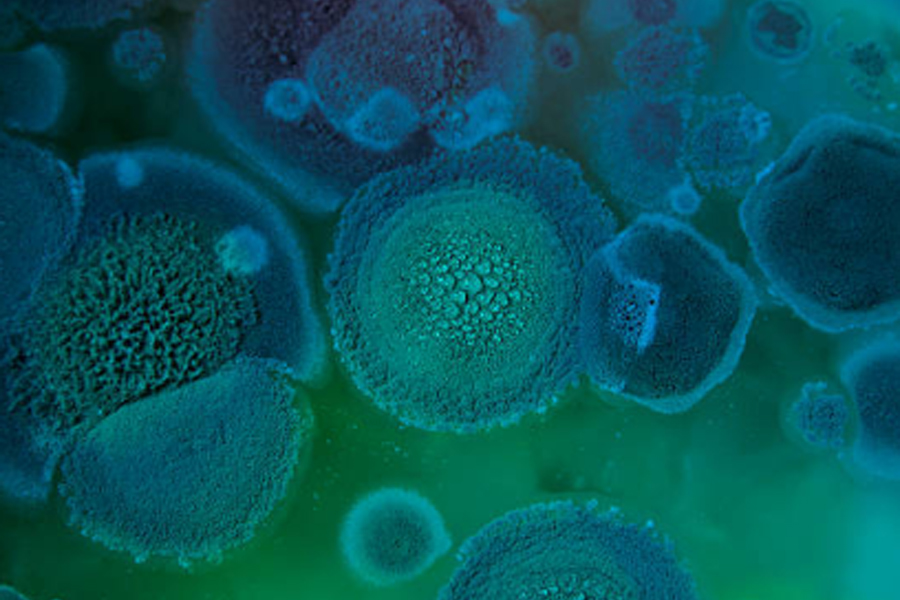
22-1.jpg

在生物技術(shù)和生物工程領(lǐng)域,微生物細(xì)胞內(nèi)含有眾多有價值的生物活性物質(zhì),如蛋白質(zhì)、酶、核酸等。然而,要獲取這些物質(zhì),首先需要破碎微生物細(xì)胞。超高壓微射流技術(shù)作為一種先進的細(xì)胞破碎手段,正逐漸成為該領(lǐng)域的研究熱點,其在優(yōu)化微生物細(xì)胞破碎效率方面有著獨特的策略和顯著的優(yōu)勢。
微生物細(xì)胞猶如一個個微小的 “工廠”,內(nèi)部蘊含著豐富的生物產(chǎn)品。例如,某些細(xì)菌細(xì)胞內(nèi)的特定酶可用于制藥工業(yè)生產(chǎn)藥物,酵母細(xì)胞中的蛋白質(zhì)可應(yīng)用于食品加工。但這些生物活性物質(zhì)被細(xì)胞壁和細(xì)胞膜所包裹,若不將細(xì)胞破碎,難以將其高效提取和利用。因此,找到一種高效、溫和且能最大程度保留生物活性物質(zhì)活性的細(xì)胞破碎方法至關(guān)重要。
超高壓微射流技術(shù)是基于高壓流體力學(xué)原理。首先,將含有微生物細(xì)胞的懸浮液通過高壓泵加壓至超高壓力,一般可達(dá)到幾十甚至上百兆帕。然后,高壓液體被強制通過微小的噴嘴,形成高速射流。這些射流在特定的反應(yīng)腔室內(nèi)相互碰撞、剪切,產(chǎn)生強烈的機械力、空化效應(yīng)和湍流等現(xiàn)象。這種強大的物理作用施加于微生物細(xì)胞上,能夠使細(xì)胞壁和細(xì)胞膜破裂,從而釋放出細(xì)胞內(nèi)的生物活性物質(zhì)。
優(yōu)化破碎效率的策略
壓力調(diào)控:壓力是超高壓微射流技術(shù)中影響細(xì)胞破碎效率的關(guān)鍵因素之一。適當(dāng)提高壓力能夠增加射流的能量和剪切力,更有效地破壞細(xì)胞結(jié)構(gòu)。但壓力過高可能導(dǎo)致生物活性物質(zhì)過度降解或失活。因此,需要根據(jù)不同的微生物種類和目標(biāo)生物活性物質(zhì)的特性,精確地確定最佳壓力范圍。例如,對于較為脆弱的革蘭氏陰性菌,相對較低的壓力可能就足以實現(xiàn)高效破碎,而對于細(xì)胞壁較厚的革蘭氏陽性菌,則可能需要更高的壓力。
處理次數(shù)與循環(huán):多次處理或循環(huán)處理可以提高細(xì)胞破碎的程度。單次通過超高壓微射流裝置可能無法完全破碎所有細(xì)胞,通過增加處理次數(shù)或使細(xì)胞懸浮液循環(huán)經(jīng)過裝置,可以使更多的細(xì)胞受到充分的破碎作用。但同時也要考慮到多次處理可能帶來的成本增加和生物活性物質(zhì)損失的問題,需要找到一個平衡點。
懸浮液濃度與性質(zhì):微生物細(xì)胞懸浮液的濃度和性質(zhì)對破碎效率也有顯著影響。合適的細(xì)胞濃度能夠確保射流在處理過程中有足夠的細(xì)胞可供作用,同時避免因濃度過高導(dǎo)致的射流堵塞或處理不均勻。此外,懸浮液的 pH 值、離子強度等性質(zhì)也會影響細(xì)胞的穩(wěn)定性和破碎效果,需要進行優(yōu)化調(diào)整。例如,某些微生物在特定的 pH 環(huán)境下細(xì)胞壁結(jié)構(gòu)會發(fā)生變化,從而影響破碎的難易程度。

超高壓微射流技術(shù)的優(yōu)勢
與傳統(tǒng)的細(xì)胞破碎方法如機械研磨、超聲破碎等相比,超高壓微射流技術(shù)具有諸多優(yōu)勢。它是一種相對溫和的破碎方式,能夠減少生物活性物質(zhì)因過度機械作用或局部過熱而導(dǎo)致的失活。同時,該技術(shù)破碎效率高、處理速度快,可以實現(xiàn)大規(guī)模連續(xù)化生產(chǎn),有利于工業(yè)應(yīng)用。而且,超高壓微射流技術(shù)在破碎過程中產(chǎn)生的雜質(zhì)相對較少,后續(xù)的分離純化步驟也相對簡單。
超高壓微射流技術(shù)通過多種策略優(yōu)化微生物細(xì)胞破碎效率,以其獨特的優(yōu)勢在生物技術(shù)領(lǐng)域占據(jù)著重要的地位,為微生物資源的開發(fā)利用提供了強有力的工具。
超高壓微射流均質(zhì)設(shè)備:讓牛初乳營養(yǎng)“物盡其用”
HiLock 海洛克超高壓微射流均質(zhì)機,破解牛初乳結(jié)塊、營養(yǎng)流失、吸收差難題!納米級顆粒細(xì)化、95%以上IgG 活性保留,沖調(diào)快速溶解無分層,純物理低溫處理無添加劑。國產(chǎn)設(shè)備成本降 20%,適配規(guī)?;a(chǎn),助力乳企搶占功能性乳品市場。
獼猴桃果漿加工新路徑:HPP 超高壓平衡品質(zhì)與滅菌
HiLock 海洛克 HPP 超高壓冷殺菌技術(shù),破解獼猴桃果漿加工兩難!400-600MPa 純物理滅菌,維生素 C 留存率達(dá) 98.5%,保留天然亮綠色與 95% 香氣,無防腐劑可延長保質(zhì)期至 14 周。國產(chǎn)設(shè)備維護成本低 40%,通過權(quán)威認(rèn)證,契合清潔標(biāo)簽趨勢,引領(lǐng)果蔬加工行業(yè)升級。
生蠔脫殼效率低、蠔肉破損、滅菌繁瑣?超高壓 HPP 滅菌設(shè)備輕松破解!HiLock 海洛克設(shè)備實現(xiàn)脫殼滅菌一體化,開殼率 100%、得率 96.57%,低溫保味還降本。15 年技術(shù)積淀,價低進口 35%,適配全場景!
HiLock超高壓微射流均質(zhì)設(shè)備:石墨烯應(yīng)用關(guān)鍵
HiLock超高壓微射流均質(zhì)設(shè)備(石墨烯分散機)精準(zhǔn)解決石墨烯團聚難題!以60000psi高壓驅(qū)動漿料通過金剛石微通道,借剪切力等剝離團聚片層,制得2-9層、200nm內(nèi)納米顆粒。自主控溫控壓系統(tǒng)保障結(jié)構(gòu)完整與性能保留,適配實驗室至工業(yè)生產(chǎn)(每小時500升),防堵+在線清洗設(shè)計提效降本,助力石墨烯工業(yè)化應(yīng)用。
HPP 超高壓滅菌設(shè)備:讓黃皮汁告別 “夏日限定”
南方特色水果黃皮制成的黃皮汁因保鮮期短成 “夏日限定”,傳統(tǒng)加工問題多。HPP 超高壓滅菌設(shè)備帶來轉(zhuǎn)機,不僅延長保質(zhì)期,還保留營養(yǎng)與風(fēng)味,看它如何讓黃皮汁突破地域與季節(jié)限制。
HPP 超高壓滅菌:盒馬 “白馬王子湯” 的品質(zhì)密碼
HPP超高壓滅菌賦能盒馬白馬王子湯,純物理冷殺菌不破壞螺旋藻天然色素與營養(yǎng),解決傳統(tǒng)高溫致色澤暗淡、營養(yǎng)流失問題,45天長保及無防腐劑,首發(fā)即6000人搶購。
超高壓HPP技術(shù):賦能羊肚加工的安全與品質(zhì)升級
針對羊肚加工難平衡安全與品質(zhì)的痛點,超高壓 HPP 技術(shù)用 100-600MPa 物理高壓殺菌,無化學(xué)添加契合清潔標(biāo)簽。低溫處理保脆嫩口感與營養(yǎng),4℃冷藏保質(zhì)期延至 30 天 +,還能助力腌制入味,適配預(yù)制菜與醬鹵羊肚加工。